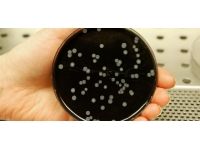
Arjantin'de bir klinikte legionella bakterisinin yol açtığı zatürreden 6 kişi öldü

DÜNYA
 05 Eylül 2022 Pazartesi 22:13Almanya, Ukrayna'nın açtığı soykırım davasına katılmak istiyorAlmanya, Ukrayna'nın Rusya'ya karşı açtığı soykırım davasına katılmak istiyor.
05 Eylül 2022 Pazartesi 22:13Almanya, Ukrayna'nın açtığı soykırım davasına katılmak istiyorAlmanya, Ukrayna'nın Rusya'ya karşı açtığı soykırım davasına katılmak istiyor. Arjantin'de bir klinikte legionella bakterisinin yol açtığı zatürreden 6 kişi öldü05 Eylül 2022 Pazartesi 20:53
Arjantin'de bir klinikte legionella bakterisinin yol açtığı zatürreden 6 kişi öldü05 Eylül 2022 Pazartesi 20:53 Çinli şirketin geliştirdiği "solunabilir" COVID-19 aşısına onay verildi05 Eylül 2022 Pazartesi 20:33
Çinli şirketin geliştirdiği "solunabilir" COVID-19 aşısına onay verildi05 Eylül 2022 Pazartesi 20:33 Rusya, ABD Ticaret Bakanı ve bazı Hollywood oyuncularına ülkeye giriş yasağı koyduRusya Dışişleri Bakanlığı, ABD Ticaret Bakanı Gina Raimondo, Hollywood oyuncuları Sean Penn ve Benjamin Edward Meara Stiller’ın bulunduğu 25 ABD vatandaşı hakkında yaptırım kararı alındığını05 Eylül 2022 Pazartesi 20:03
Rusya, ABD Ticaret Bakanı ve bazı Hollywood oyuncularına ülkeye giriş yasağı koyduRusya Dışişleri Bakanlığı, ABD Ticaret Bakanı Gina Raimondo, Hollywood oyuncuları Sean Penn ve Benjamin Edward Meara Stiller’ın bulunduğu 25 ABD vatandaşı hakkında yaptırım kararı alındığını05 Eylül 2022 Pazartesi 20:03 AB, Putin'i enerjiyi silah olarak kullanmakla suçladıAvrupa Birliği (AB) Komisyonu Başkanı Ursula von der Leyen, Rusya Devlet Başkanı Vladimir Putin'in arzı keserek ve piyasaları manipüle ederek enerjiyi bir silah olarak kullandığını aktardı.05 Eylül 2022 Pazartesi 19:53
AB, Putin'i enerjiyi silah olarak kullanmakla suçladıAvrupa Birliği (AB) Komisyonu Başkanı Ursula von der Leyen, Rusya Devlet Başkanı Vladimir Putin'in arzı keserek ve piyasaları manipüle ederek enerjiyi bir silah olarak kullandığını aktardı.05 Eylül 2022 Pazartesi 19:53 AB, İran nükleer anlaşmasında yakında bir sonuç beklemiyorAvrupa Birliği (AB) Dış İlişkiler ve Güvenlik Politikası Yüksek Temsilcisi Josep Borrell, ABD'nin İran ile nükleer anlaşmaya dönmesi konusunda hızlı bir mutabakat beklemediğini, düne göre bir anlaşma ihtimalinin daha az olduğunu söyledi.05 Eylül 2022 Pazartesi 19:53
AB, İran nükleer anlaşmasında yakında bir sonuç beklemiyorAvrupa Birliği (AB) Dış İlişkiler ve Güvenlik Politikası Yüksek Temsilcisi Josep Borrell, ABD'nin İran ile nükleer anlaşmaya dönmesi konusunda hızlı bir mutabakat beklemediğini, düne göre bir anlaşma ihtimalinin daha az olduğunu söyledi.05 Eylül 2022 Pazartesi 19:53 Nijerya'da 200'den fazla Boko Haram üyesi etkisiz hale getirildiNijerya'nın kuzeydoğusunda terör örgütü Boko Haram ve ISWAP'a yönelik operasyonlarda 200'den fazla terörist etkisiz hale getirildi.05 Eylül 2022 Pazartesi 18:43
Nijerya'da 200'den fazla Boko Haram üyesi etkisiz hale getirildiNijerya'nın kuzeydoğusunda terör örgütü Boko Haram ve ISWAP'a yönelik operasyonlarda 200'den fazla terörist etkisiz hale getirildi.05 Eylül 2022 Pazartesi 18:43 İtalya'da aşırı sağcı lider Salvini, Rusya'ya uygulanan yaptırımlara karşı çıkıyorİtalya'da aşırı sağcı Lig partisinin lideri Matteo Salvini, Ukrayna savaşından dolayı Avrupa Birliği'nin (AB) Rusya'ya uyguladığı ekonomik yaptırımlara karşı çıkan söylemlerine devam etti.05 Eylül 2022 Pazartesi 18:43
İtalya'da aşırı sağcı lider Salvini, Rusya'ya uygulanan yaptırımlara karşı çıkıyorİtalya'da aşırı sağcı Lig partisinin lideri Matteo Salvini, Ukrayna savaşından dolayı Avrupa Birliği'nin (AB) Rusya'ya uyguladığı ekonomik yaptırımlara karşı çıkan söylemlerine devam etti.05 Eylül 2022 Pazartesi 18:43 Ukrayna, gaz stokunun bir kısmını AB'ye verecekUkrayna Başbakanı Denis Şmıgal, Ukrayna'nın 30 milyar metkeküplük doğal gaz stoklarının bir kısmını AB ülkelerine göndereceğini söyledi.05 Eylül 2022 Pazartesi 18:33
Ukrayna, gaz stokunun bir kısmını AB'ye verecekUkrayna Başbakanı Denis Şmıgal, Ukrayna'nın 30 milyar metkeküplük doğal gaz stoklarının bir kısmını AB ülkelerine göndereceğini söyledi.05 Eylül 2022 Pazartesi 18:33 NSA'nın Çin üniversitesini siber casusluk için hedef aldığı iddia edildiABD Ulusal Güvenlik Ajansı (NSA) ile bağlantılı bilgisayar korsanlarının, Çin'in Kuzeydoğu Politeknik Üniversitesi'nden bilimsel ve teknolojik bilgi sızdırmak amacıyla örgütlü siber casusluk faaliyetinde bulunduğu öne sürüldü.05 Eylül 2022 Pazartesi 18:33
NSA'nın Çin üniversitesini siber casusluk için hedef aldığı iddia edildiABD Ulusal Güvenlik Ajansı (NSA) ile bağlantılı bilgisayar korsanlarının, Çin'in Kuzeydoğu Politeknik Üniversitesi'nden bilimsel ve teknolojik bilgi sızdırmak amacıyla örgütlü siber casusluk faaliyetinde bulunduğu öne sürüldü.05 Eylül 2022 Pazartesi 18:33 Zimbabve'de kızamık salgınında ölen çocukların sayısı 698'e yükseldiGüney Afrika ülkesi Zimbabve'de görülen kızamık salgınında nisandan bu yana 698 çocuğun hayatını kaybettiği aktarıldı.05 Eylül 2022 Pazartesi 18:23
Zimbabve'de kızamık salgınında ölen çocukların sayısı 698'e yükseldiGüney Afrika ülkesi Zimbabve'de görülen kızamık salgınında nisandan bu yana 698 çocuğun hayatını kaybettiği aktarıldı.05 Eylül 2022 Pazartesi 18:23 İngiliz danışmanlık şirketi: Enflasyon ve savaş toplumsal çatışma riskini artırdıİngiliz danışmanlık şirketi Verisk Maplecroft, yüksek enflasyon ve Ukrayna'da devam eden savaşın oluşturduğu olumsuz koşulların gelecekte pek çok ülkede çatışma riskini artırdığını duyurdu.05 Eylül 2022 Pazartesi 18:13
İngiliz danışmanlık şirketi: Enflasyon ve savaş toplumsal çatışma riskini artırdıİngiliz danışmanlık şirketi Verisk Maplecroft, yüksek enflasyon ve Ukrayna'da devam eden savaşın oluşturduğu olumsuz koşulların gelecekte pek çok ülkede çatışma riskini artırdığını duyurdu.05 Eylül 2022 Pazartesi 18:13- Zaporijya Nükleer Santrali'nin Ukrayna elektrik şebekesiyle son bağlantısı kesildi05 Eylül 2022 Pazartesi 17:43
- Sırbistan Başbakanı Brnabic Kosova’da05 Eylül 2022 Pazartesi 17:43
- İsrail, yabancıların Batı Şeria'ya girişlerini kısıtlamaya hazırlanıyor05 Eylül 2022 Pazartesi 17:23
- Belçika Başbakanı De Croo: Savaş ekonomisine girme riskimiz var05 Eylül 2022 Pazartesi 17:03
- Truss: Ekonomimizi büyütecek cesur bir plan sunacağım05 Eylül 2022 Pazartesi 16:53
- İsrail'den öldürülen gazeteci ile ilgili açıklama: İsrail ordusunun ateşiyle öldürülmüş olma olasılığı yüksek05 Eylül 2022 Pazartesi 16:43
- ABD'de deniz uçağı düştü: 1 kişi öldü, 9 kişi kayıp05 Eylül 2022 Pazartesi 15:13
- AB yüksek enerji fiyatlarını azaltmak için acil önlemler almaya hazırlanıyor05 Eylül 2022 Pazartesi 14:53
- İngiltere'nin yeni Başbakanı Liz Truss oldu05 Eylül 2022 Pazartesi 14:48
- Almanya'daki orman yangınına havadan müdahale ediliyor05 Eylül 2022 Pazartesi 14:23
- Kremlin'den Kuzey Akım'da durdurulan sevkiyatlarla ilgili açıklama yaptı05 Eylül 2022 Pazartesi 13:43
- Rusya: Kabil'deki patlamada 2 misyon çalışanımız öldü05 Eylül 2022 Pazartesi 13:43
- Kazakistan Cumhurbaşkanı Tokayev orman yangını bölgesinde05 Eylül 2022 Pazartesi 13:33
- BM: Somali'de kıtlık kapıda05 Eylül 2022 Pazartesi 13:23
- TurAz Kartalı 2022 tatbikatı Azerbaycan'da başladı05 Eylül 2022 Pazartesi 13:23
- Avrupa'da doğal gaz fiyatlarındaki artış sürüyor05 Eylül 2022 Pazartesi 13:23
- İran'da 5,4 büyüklüğünde deprem05 Eylül 2022 Pazartesi 13:13
- Fransa: Türkiye bölgede aktif rol oynuyor05 Eylül 2022 Pazartesi 13:03
- İspanya'dan Almanya'ya giderken düşen uçaktakilerin kimlikleri belli oldu05 Eylül 2022 Pazartesi 12:53
- Güney Kore'de tayfun sebebiyle uçuşlar ve feribot seferleri durduruldu05 Eylül 2022 Pazartesi 12:23
1/20
- 22:26 - Emekliye ayrılan ve 30 hizmet yılını tamamlayan polislere plaket verildi
- 22:08 - Meclis Genel Kurulu tamamlandı… Atatürk Öğretmen Akademisi Kuruluş (Değişiklik) Yasa Tasarısı kabul edildi
- 21:13 - Erhürman: “Halkımızın çözüm iradesi çerçevesinde Genel Sekreter’in çabalarını destekliyoruz”
- 19:45 - Çalışma Bakanlığı: “Siber saldırıda herhangi bir veri kaybı veya veri sızıntısı yaşanmadı”
- 17:08 - Genel Kurul’da yeniden görüşülen Konut Edindirme (Değişiklik) Yasası, oy çokluğuyla kabul edildi
- 15:13 - DAÜ sporcusu Ada Kafa, U18 Türkiye Şampiyonu oldu
- 14:33 - Geçitkale-Yıldırım arasında yangın
- 13:03 - 54.Geleneksel İskele Festivali 26 Haziran’da başlıyor
- 12:58 - AÖA Yasa Tasarısı’na tepki
- 12:53 - Şehit Teğmen Caner Gönyeli-2026 Arama Kurtarma Davet Tatbikatı başladı
- 12:53 - Meclis Genel Kurulu toplandı
- 11:25 - Karaoğlanoğlu Spor Oyunları ve Deniz Şenliği başlıyor
- 10:33 - “Keçenin Yolculuğu” videosu İtalya’da birinci oldu
- 10:33 - ‘Dünya Yoga Günü’ kapsamında Girne’de etkinlik gerçekleştirildi
- 09:45 - ABD ve İran ‘Hürmüz’ konusunda anlaştı
SPOR
Tüm Hakları Saklıdır © 2013 Ada Haber | İzinsiz ve kaynak gösterilmeden yayınlanamaz.






























































